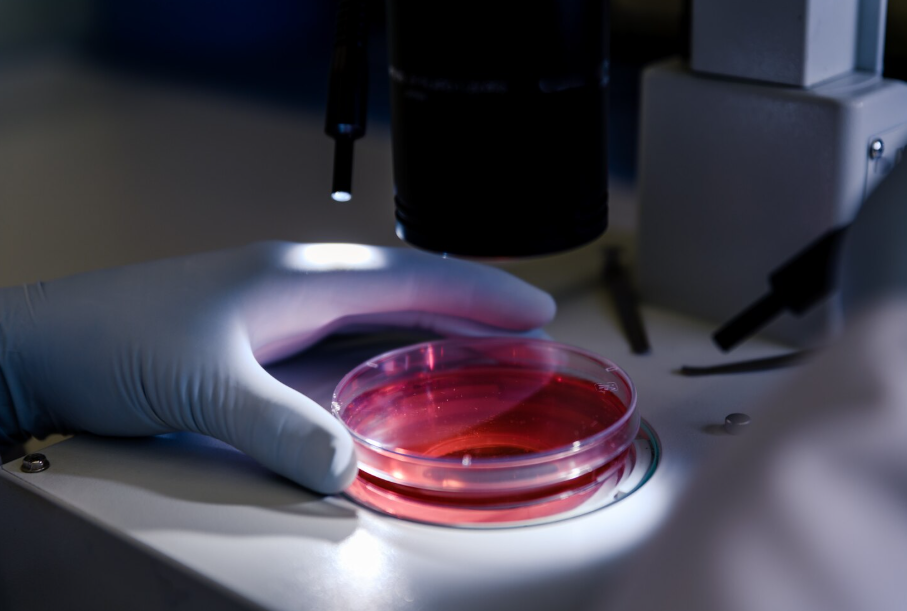

Лабораторная диагностика стремительно развивается, открывая новые возможности для раннего выявления заболеваний и более точного мониторинга состояния пациентов. Современные технологии позволяют не только ускорить получение результатов, но и значительно повысить их информативность. Уже сегодня в клинической практике активно применяются инновационные решения, включая тромбоэластограф, которые меняют привычный подход к анализу крови и делают диагностику более глубокой и персонализированной.
Новые технологии в анализе крови
Одним из ключевых направлений развития лабораторной диагностики является внедрение автоматизированных и цифровых систем. Они позволяют минимизировать влияние человеческого фактора и обеспечить высокую точность результатов. Современные анализаторы способны одновременно оценивать десятки параметров, что существенно сокращает время диагностики.
Кроме того, активно развиваются методы, позволяющие изучать кровь в динамике. Это особенно важно при лечении хронических заболеваний, когда необходимо отслеживать изменения показателей в режиме реального времени. Такие технологии дают возможность врачам своевременно корректировать терапию и предотвращать осложнения.
Преимущества инновационных методов диагностики
Переход к новым технологиям анализа крови приносит значительные преимущества как для пациентов, так и для медицинских учреждений. Улучшается качество диагностики, повышается скорость принятия решений и снижается риск ошибок.
К основным преимуществам можно отнести:
- высокую точность и воспроизводимость результатов;
- сокращение времени проведения анализов;
- возможность комплексной оценки состояния организма;
- снижение нагрузки на медицинский персонал;
- улучшение контроля за течением заболеваний.
Благодаря этим факторам современные методы диагностики становятся важным инструментом в персонализированной медицине.
Перспективы развития лабораторной диагностики
Будущее лабораторной медицины связано с дальнейшей интеграцией цифровых технологий, искусственного интеллекта и биоинженерии. Уже сейчас разрабатываются системы, способные автоматически интерпретировать результаты анализов и предлагать возможные варианты лечения.
Особое внимание уделяется созданию компактных устройств для экспресс-диагностики, которые можно использовать вне лабораторий. Это открывает новые возможности для телемедицины и позволяет проводить обследования в домашних условиях.
Таким образом, новые технологии кардинально меняют подход к анализу крови, делая его более точным, быстрым и доступным. Внедрение инновационных решений способствует повышению качества медицинской помощи и формирует основу для медицины будущего, ориентированной на индивидуальные потребности каждого пациента.